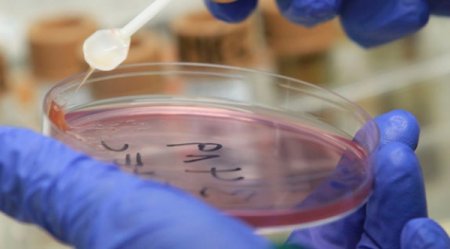
Ситуация в Новоуткинске полностью стабилизировалась

Ситуация в Новоуткинске полностью стабилизировалась
|
Рабочий день в администрации городского округа Первоуральск начался с заседания санитарно-противоэпидемической комиссии, на котором анализировалась ситуация в поселке Новоуткинск, где неделю назад за медицинской помощью обратились несколько взрослых и детей разного возраста с жалобами на плохое самочувствие.
Представители здравоохранения, полиции, прокуратуры, управления образования, «Водоканала», контролирующих органов отчитывались перед Еленой Рожковой, заместителем главы администрации по управлению социальной сферой, о принятых мерах и работе, проведенной в праздничные дни.
Участие в работе комиссии принял Алексей Дронов, глава администрации городского округа Первоуральск. Практически все праздничные дни глава администрации провел в поселке Новоуткинск, где лично руководил работами по дезинфекции объектов и снабжению населения качественной питьевой водой.
Напомним, 25 апреля в поселке Новоуткинск за медицинской помощью обратились несколько взрослых и детей разного возраста, с жалобами на плохое самочувствие. За последующие дни всего заболели 60 детей и подростков. В 12 случаях лабораторные исследования подтвердили диагноз «дизентерия».
В настоящий момент в стационаре первоуральской больницы остаются 16 человек. Состояние у всех хорошее. Детей готовят к выписке.
Новых случаев заболевания, к счастью, нет. Пик заболеваемости пройден. Администрация городского округа полностью контролирует ситуацию.
В период с 25 апреля по 5 мая, по оценке Алексея Дронова, администрация городского округа Первоуральск, управление образования, управление здравоохранения, СТУ и все причастные городские службы проделали колоссальную работу.
Были проведены неоднократные дезинфекции детского сада и школы №26. В школе установлена новая система фильтрации воды. Закуплена новая посуда. В ближайшие дни будет приобретен новый электрокипятильник для кипячения воды. Его стоимость 85 000 рублей. Деньги выделяет управление образования городского округа Первоуральск.
Безусловно, выполнены все предписания Роспотребнадзора.
Многое сделано для улучшения качества питьевой воды в системе водоснабжения поселка Новоуткинск. Проведена дезинфекция и хлорирование водопроводной сети, очищена санитарно-защитная зона источника водоснабжения, из лучшей по качеству скважины в селе Крылосово организован подвоз питьевой воды в Новоуткинск, сообщили в пресс-службе Администрации.
Из всех источников питьевой воды организован отбор проб каждые 12 часов. Пробы воды специалисты «Водоканала» отвозят в Екатеринбург в сертифицированную лабораторию.
Несмотря на то, что проведенные Роспотребнадзором многочисленные анализы не указали прямой источник распространения заболевания, в Новоуткинске было сделано все, для того, чтобы остановить и предотвратить распространение заболеваемости.
В протоколе заседания сегодняшней санитарно-противоэпидемической комиссии записано, что администрация городского округа Первоуральск выполнила и продолжает исполнять все предписания Роспотребнадзора.
@ www.pervo.ru
